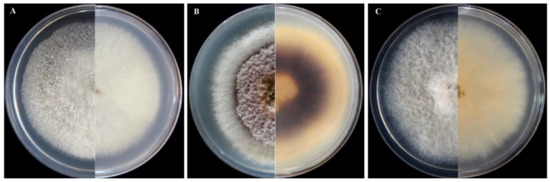

Abstract
Infections by Fusarium and Fusarium-like species on cacti and other succulent plants cause the syndrome known as Fusarium dry rot and soft rot. There are only few records of Fusarium species as pathogens of cacti and other succulent plants from Iran. The objective of this study was the identification and characterization of fusarioid species recovered from ornamental succulents in Shiraz County, Iran. Three fusarioid species, including F. oxysporum, F. proliferatum, and Neocosmospora falciformis (formerly F. falciforme), were recovered from 29 diverse species of cacti and other succulents with symptoms of Fusarium dry rot and soft rot. The three fungal species were identified on the basis of morphological characters and the phylogenetic analysis of the translation elongation factor1-α (tef1) nuclear gene. The F. oxysporum isolates were identified as F. oxysporum f. sp. opuntiarum. The pathogenicity of the three fusarioid species was tested on a range of economically important ornamental succulents, mostly in the Cactaceae family. The three species showed a broad host spectrum and induced different types of symptoms on inoculated plants, including soft and dry rot, chlorosis, necrotic spots, wilt, drying, root and crown rot. This is the first report of N. falciformis as a pathogen of succulent plants worldwide.
1. Introduction
There are diverse definitions of succulent plants [1]. In accordance with an inclusive concept, succulent plants are characterized by fleshy tissues adapted to water storage. Some succulents, such as cacti, store water in the stem, whereas others store water mainly in the leaves. Most succulents are native to arid regions and consequently show some degree of xerophytic adaptation, such as a modified cycle of CO2 fixation called crassulacean acid metabolism. Succulent plants are found in more than 60 plant families, including Aizoaceae, Asclepiadaceae, Crassulaceae, Euphorbiaceae, and Cactaceae, to cite the most numerous ones [2,3,4,5]. The Cactaceae family comprises four subfamilies, 127 genera, and more than 2000 species [6]. Species in this family are economically relevant as ornamental, landscape, medicinal, and crop plants [7,8]. Succulent plants are susceptible to various plant pathogens [9,10,11,12]. Among them, soil-borne fungi of the genus Fusarium and its allied genera stand out for the severe losses they cause on ornamental cacti in greenhouse [11].
The identification of Fusarium species is challenging, as the taxonomy and nomenclature of this genus has been in a continuous flux since its first description. Recently, phylogenetic criteria were introduced to revise the taxonomy of this genus, and as a consequence, a more restricted concept of Fusarium was defined, and new genera, such as Neocosmospora, were segregated from Fusarium sensu lato [12,13]. However, there are conflicting opinions and an ongoing, lively debate on whether to keep these new genera separate from Fusarium sensu stricto or merge all fusarioid species in a single genus, conforming with a broad concept of Fusarium [14,15,16]. Translation elongation factor1-α (tef1) was shown to be a suitable barcode for resolving species of Fusarium and allied genera [13]. The definition and identification of formae speciales (ff. spp.) of Fusarium are even more challenging [17]. The concept of forma specialis (f. sp.) was initially restricted to a single plant species and subsequently was broadened to include strains with the same host range [17]. Fusarium oxysporum f. sp. opuntiarum (Pettinari) W.L. Gordon, for example, is one of the more than 140 recognized formae speciales of F. oxysporum von Schlechtendal emend. Snyder and Hansen; presently, its host range encompasses succulent plants in the family Cactaceae and Euphorbiaceae, including Astrophytum myriostigma Lem., Cereus spp., Echinocactus grusonii Moran, Espostoa lanata (Kunth) Britton and Rose, Euphorbia mammilaris L., Ferocactus latispinus (Haworth) Britton and Rose, Mammillaria zeilmanniana Boed., Opuntia ficus-indica (L.) Mill. and Schlumbergera truncata Moran [11,17]. Beside F. oxysporum f. sp. opuntiarum, other Fusarium ff. spp. and species were reported as pathogens of succulent plants, including F. oxysporum f. sp. crassulae; F. oxysporum f. sp. echeveriae; F. equiseti (Corda) Sacc.; F. fujikuroi, the anamorph of Giberella fujikuroi (Sawada) Wollenw.; F. lunatum (Ellis and Everh.) Arx, now Bisifusarium lunatum (Ellis and Everh.) L. Lombard and Crous; and F. proliferatum (Matsush.) Nirenberg ex Gerlach and Nirenberg, a species in the F. fujikuroi species complex (FFSC) [9,18,19,20,21]. There are also reports of F. oxysporum as a pathogen of succulents, such as Agave tequilana F.A.C. Weber (family Asparagaceae sensu lato), Aloe barbadensis Miller (family Aloeaceae), Echinopsis oxygona Link. (Zucc.) ex Pfeiff. and Otto (family Cactaceae), and Hylocereus undatus (family Cactaceae), but without any evidence of a f. sp. involved [22,23,24,25].
Neocosmospora (Hypocreales, Nectriaceae), quite recently segregated as a distinct genus from the F. solani species complex (FSSC), includes ubiquitous fungi with a worldwide distribution that are usually found in soil, plant debris, living plant material, air, and water. It comprises both plant and human pathogens and has been isolated from nearly 500 different host plants of more than 100 families [12,13,14,15,16].
Fusarioid species survive in the soil as chlamydospores or mycelium associated with plant debris and organic matter. Although behaving prevalently as soil-borne pathogens, they may infect above ground organs of the plant by aerially dispersed conidia. Symptoms incited by fusarioid species on succulent plants are of diverse types, including soft and dry rot, root and crown rot, stem rot, chlorosis, and necrotic spots, and they are collectively referred to as Fusarium rot [11,26].
From 2017 to 2018, F. oxysporum isolates were recovered from infected tissues of succulent plants, such as Cereus sp., Echinocactus sp., Ferocactus sp., Notocactus sp. and Opuntia sp., under greenhouses in Iran. Subsequently, these isolates were identified as F. oxysporum f. sp. opuntiarum [27]. In the last years, symptoms suggestive of Fusarium soft and dry rot have frequently been observed on several cacti and other succulent plants in commercial greenhouses for the production of ornamentals in Shiraz County, Fars Province, Iran. The main objectives of this study were to identify the Fusarium and Fusarium-like species associated with these symptoms and to investigate the ability of these fungi to infect different species of succulent plants.
2. Materials and Methods
2.1. Isolation of Fungi
To identify the causal agents of Fusarium rot of succulent plants in commercial greenhouses for the production of ornamentals in Shiraz County, during 2017–2018, infected root crown and stem tissues from symptomatic potted plants were collected in the municipalities of Shiraz, Bajgah, and Sadra. The coordinates of sampling sites were recorded by Global Positioning System (GPS) (Table 1). Root and rhizosphere soil samples were brought to the Mycology Laboratory of the Department of Plant Protection, Shiraz University. To isolate fusarioid species, root and symptomatic crown tissues were put into Erlenmeyer flasks containing sterile distilled water (SDW) on a shaker device for 30 min, and the water was replaced every 10 min. After washing, the tissues were immersed in sodium hypochlorite 0.5% for 10 s, and after re-washing with SDW for 5 to 6 h, they were placed on sterile paper towels for drying. Then, they were cut into small segments or blocks (5 mm) and placed in Petri dishes on Potato-Dextrose-Agar medium amended with streptomycin (PDA; Oxoid Ltd., Basingstoke, UK; streptomycin 200 µg/mL) [28]. After 3 to 5 days incubation at 24 °C, mycelium plugs were transferred to water agar medium (WA; agar 10 g/L). Isolates were purified by single-spore subculture on WA according with a standard protocol [29] and stored on PDA slopes at 4 °C.

Table 1.
Fusarioid species isolates recovered from ornamental cacti and other succulent plants collected in commercial greenhouses of Shiraz County, Iran.
2.2. Morphological Characterization
All isolates were characterized based on their cultural and morphological characteristics. Colony morphology, pigmentation, and type of aerial mycelium were determined on PDA. Morphological observations included the presence and characteristics of sporodochia, size of sporodochial (macro-) and aerial (micro-) conidia, shape and degree of septation of conidia; disposition of the microconidia; and conidiophore length and branching patterns, type of the conidiogenous cells, and presence or absence of chlamydospores, according with standard protocols [30,31]. To produce sporodochia, agar blocks from single-spore cultures were placed in Petri dishes (60 mm diameter) on carnation leaf-piece agar (CLA) medium prepared according to the Fusarium Laboratory Manual [32]. Carnation leaves were cut into pieces (5 × 5 mm), dried at 60 °C for 24 h, sterilized by autoclaving, and placed on nearly solid 1.5% WA. Petri dishes were incubated at 25 °C for 7–14 d under 12 h cool fluorescent light/dark cycles. To produce microconidia, cultures were prepared on KCLA (carnation leaf agar supplemented with 8 g/L of potassium chloride) [33] agar medium by transferring agar blocks of 5 × 5 mm from cultures grown on CLA [32] immediately after the production of sporodochia. Chlamydospore formation was checked on cultures growing on PDA, CLA, KCLA, and synthetic nutrient-poor agar (SNA) [32,33] with and without sterilized pieces of carnation leaves, incubated at room temperature with a 12 h cool fluorescent light/dark photoperiod [32,34,35]. Slide preparations for microscopical observations were mounted in water. Isolates were identified using morphological identification keys [32,36].
2.3. DNA Extraction, PCR, Sequencing, and Phylogenetic Analyses
A more restricted number of selected isolates was identified by phylogenetic analysis of the translation elongation factor1-α (tef1) nuclear gene. The DNA was extracted from 0.5 × 0.5 mm fungal blocks from 5-day-old colonies on PDA according to the protocol of Schena et al. [37]. The extracted DNA was kept at −20 °C for further studies. DNA quality was examined with an MD-1000 Nanodrop spectrophotometer (Nanodrop Technologies, DE, USA) [37]. The translation elongation factor1-α (tef1) gene was amplified with the pair primers TEF1 (5′ATGGGTAAGGARGACAAGAC3′) and TEF2 (5′GGARGTACCAGTSATCTG3′) according to O’Donnell et al. [38]. The amplification conditions for tef1 were: 95 °C for 3 min, 35 cycles for 94 °C for 60 s, 55 °C for 30 s, 72 °C for 90 s, and 72 °C for 10 min. The PCR products were sequenced with the primers used for amplification by a dye terminator cycle (Shahid Rajaie Cardiovascular, Medical, and Research Center, Tehran, Iran). The resulting sequences were submitted to GenBank and acquired accession numbers are listed in Table 2. Raw sequences were edited by BioEdit [39], and sequence alignment was performed by Clustal X with subsequent visual adjustments [40].

Table 2.
Species of succulent plants that proved to be susceptible to three fusarioid fungal species in pathogenicity tests. Two diverse artificial inoculation methods were used: wound inoculation with a conidial suspension (106 conidia mL−1) and inoculation through the soil with infested wheat grains as inoculum.
Geejayessia atrofusca (Schwein.) Schroers and Gräfenhan (accession No. AF178361) was considered as an outgroup for Fusarium spp. and Neocosmospora spp. phylogenetic trees. To reconstruct the phylogenetic trees, Bayesian inference analyses on tef1 locus were carried out with MrBayes v. 3.1 [41], imposing a general time-reversible (GTR) substitution model with gamma (G) and proportion of invariable site (I) parameters to accommodate variable rates across sites. Bayesian analyses were conducted with the same data set according to Salmaninezhad and Mostowfizadeh-Ghalamfarsa [42]. The best nucleotide substitution model was determined by MrModelTest v. 2.3 [43] Two independent runs of Markov chain Monte Carlo (MCMC) using four chains were run over 1,000,000 generations. Trees were saved each 1000 generations, resulting in 10,001 trees. Burn-in was set at 5% generations. The phylogenetic tree was constructed using TrEase [44], and the resultant tree was edited and displayed with Mega 7.1 [45]. Alignments and trees were submitted to TreeBASE [46].
2.4. Pathogenicity Tests and Host Range
The same 13 isolates identified at the species level by phylogenetic analysis of the tef1 nuclear gene were evaluated for their ability to infect succulent plants. To perform pathogenicity tests, two distinct methods of inoculation were compared. In the first method, 1 mL of a conidial suspension (106 conidia per mL) was injected into each plant. Control plants were injected with SDW [27,47].
In the second method, 50 mL of autoclaved wheat seeds were placed into 250 mL Erlenmeyer flasks and inoculated with mycelium plugs (three 5 mm mycelium plugs per flask). After two weeks incubation at 25 °C, the resulting inoculum was used for root inoculation of test plants by removing the soil around the crown and placing 10 seeds colonized by the pathogen at the base of the stem. The seeds were then covered with the soil [48]. Control plants were inoculated with sterile seeds.
Potted 2- to 3-year-old plants were used in pathogenicity tests, including species of Aeonium, Astrophytum, Braunsia, Carnegiea, Cephalocereus, Cereus, Echeveria, Echinocactus, Echinocereus, Ferocactus, Gymnocalycium, Hamatocactus, Mammillaria, Notocactus, Opuntia, Sedum, and Sempervivum. Plants were grown in greenhouse at temperature ranging from 22 to 26 °C and were examined for the presence of symptoms up to 40 days post inoculation (d.p.i.).
3. Results
3.1. Sampling
Overall, 29 species of succulent plants belonging to 10 diverse genera of the families Cactaceae and Crassulaceae and showing symptoms of crown and root rot were sampled during the survey (Table 1). Basically, the symptoms were of two types: dry rot and soft rot. Dry rot was prevalent on species of Aeonium, Echeveria, Ferocactus, Mammillaria, and Notocactus, while soft rot was mainly observed on species of Astrophytum, Cephalocereus, Echinocactus, Echinocereus, and Gymnocalycium. A total of 62 fusarioid isolates were obtained from symptomatic plants. Their hosts and geographic origin are reported in Table 1.
3.2. Morphological Characterization of Isolates of Fusarium and Neocosmospora Species
Despite the variability in colony morphology and micromorphological traits as well as the partial overlapping of the dimensions of micro- and macroconidia, the 62 fusarioid isolates obtained from succulent plants could be grouped into three distinct morphotypes. The most numerous group encompassed 38 isolates recovered from plants of the family Cactaceae and Crassulaceae. These isolates formed on PDA colonies that were fast-growing, uniform, with aerial mycelium denser in the center of the colony, and a diffuse pale pink pigmentation, which turned dark violet with age (Figure 1B). Sporodochial conidia produced on CLA were three septate, with mean dimensions of 30.95 × 2.84 μm (range 27 to 36 μm in length and 3.0 to 4.0 μm in width). Measures were taken on 30 macroconidia per isolate. Microconidia were oval to obovoid in shape, non-septate; conidiophores were monophialidic and chlamydospores single or double. A second morphotype comprised 17 isolates recovered from plants of the families Cactaceae and Crassulaceae. They formed on PDA colonies that were fast-growing, uniform with aerial mycelium, and a diffuse yellowish pigmentation fading to pale pink (Figure 1C). Sporodochial conidia produced on CLA were three to four septate with mean dimensions of 45.6 × 6.0 μm (range 5.1 to 41.7 μm in length and 3.2 to 9.5 μm in width). Measures were taken on 30 macroconidia per isolate. Microconidia were ellipsoid to oval in shape, 0 to 1 septate; conidiophores were prevalently monophialidic and less frequently polyphialidic; chlamydospores were absent in some isolates, while in others, they were produced in a large amount and were single-celled, terminal, and typically rough-walled. A third and less numerous group comprised seven isolates, all recovered from plants of the family Cactaceae. Colonies of these isolates growing on PDA were fast growing, floccose, and white, with no evident pigmentation (Figure 1A). Sporodochial conidia produced on CLA were straight to falcate, moderately curved and slender, sometimes strongly curved, with apical cell papillate and basal cell foot-shaped to barely notched, one to four septate, with mean dimensions of 45.6 × 3 μm (range 16.5 to 55 μm in length and 2 to 4.5 μm in width), and clustering in discrete false heads at the tip of phialides. Measures were taken on 30 macroconidia per isolate. However, a few isolates of this morphotype failed to produce sporodochia. Microconidia were ovoid to pear-shaped, prevalently non septate, and rarely one septate; sporodochial conidiogenous cells were mono- and polyphialidic; chlamydospores were absent.
Figure 1.
Colony morphology of (A) Neocosmospora falciformis (isolate FNol01); (B) Fusarium oxysporum f. sp. opuntiarum (isolate OEcg42); and (C) Fusarium proliferatum (isolate PEcg29) from succulent plants; front (left) and back (right) side after 5 days incubation on PDA at 25 °C in the dark.
Based on these morphological characteristics, the second and third groups of isolates were tentatively identified as Neocosmospora falciformis (Carrión) L. Lombard and Crous, formerly F. falciforme (Carrión) Summerb. and Schroers, and F. proliferatum (Matsush.) Nirenberg, respectively, while the first and most numerous groups was tentatively identified as F. oxysporum f. sp. opuntiarum W.L. Gordon, based on both morphological traits and the range of naturally infected host plants from which isolates were recovered, prevalently encompassing the species of Cactaceae.
3.3. Phylogenetic Analysis
Thirteen isolates, nine of the morphotype identified tentatively as F. oxysporum f. sp. opuntiarum, one from the morphotype identified tentatively as F. proliferatum, and three from the morphotype identified tentatively as N. falciformis, were selected for the phylogenetic analysis based on the translation elongation factor1-α (tef1) gene sequences. Molecular diagnosis confirmed unequivocally the identification based on morphological traits. The final alignment length was 647 bp. Each new group of isolates formed a monophyletic group in Bayesian trees (Figure 1 and Figure 2). The Bayesian posterior probability for each lineage ranged from 0.52 to 1.00. The tef1 sequences of the isolates FNol01, FGyh01, and FAeg01 clustered with reference N. falciformis isolates [13].; the sequences of isolates OMap01, OGyf01, OEep02, ONos03, ONos04, OFel11, OEcg42, OAsm31, and OAsm21 clustered with F. oxysporum f. sp. opuntiarum (MH582354, [16]); and PEcg29 clustered with F. proliferatum (MH582347, [16]), with a high posterior probability of 0.52 to 1.00 (Figure 2 and Figure 3).
3.4. Pathogenicity Tests and Host Range
On homologous test plants, all thirteen selected fungal isolates of the three identified fusarioid species (nine of F. oxysporum f. sp. opuntiarum, one of F. proliferatum, and three of N. falciformis) incited the same symptoms as those observed on plants with natural infections sampled in commercial greenhouses. Moreover, the isolates induced symptoms on numerous other artificially inoculated succulent plants (Table 2). Conversely, all control plants remained symptomless.

Figure 2.
Phylogenetic relationships of Neocosmospora falciformis isolates recovered from Shiraz County greenhouses with other N. falcifomis isolates and 56 diverse Neocosmospora species (see Sandoval-Denis et al. 2019) based on Bayesian analysis of translation elongation factor1-α (tef1) sequences. Numbers above the branches represent the posterior probability based on Bayesian analysis. Isolates retrieved from succulent plants in Iran are shown in bold.

Figure 3.
Phylogenetic relationships of Fusarium species recovered from Shiraz County greenhouses with 24 Fusarium species based on Bayesian analysis of translation elongation factor1-α (tef1) sequences. Numbers above the branches represent the posterior probability based on Bayesian analysis. Isolates retrieved from succulent plants in Iran are shown in bold (or arrows point at isolates retrieved form succulent plants in Iran).
The inoculated fungi were reisolated from symptomatic plants, thus fulfilling Koch’s postulates. Different types of symptoms were observed, such as black to dark-brown spots, yellowing and chlorosis, stunting, apical necrosis, brown to black necrotic areas on the stem, internal rotting, loss of turgor, and stem crinkle leading to plant death (Figure 4, Figure 5 and Figure 6). On all injected plants, first symptoms of rot appeared 10 days post inoculation (d.p.i.) with the only exception of Mammillaria gracilis and M. prolifera plants, inoculated with F. proliferatum, which showed first symptoms 7 d.p.i. Injected plants of these two Mammillaria species died within 10 d.p.i., while injected plants of other succulent species, including M. bernalensis, M. jaliscana, M. pottsii, and M. spinosissima, died between 16 and 30 d.p.i. All plants inoculated with the three fusarioid species through the soil showed first rot symptoms 20 d.p.i., once again with the exception of M. gracilis and M. prolifera plants, inoculated singularly with F. oxysporum f. sp. opuntiarum and F. proliferatum, which showed the first symptoms 15 d.p.i., confirming differences in susceptibility to Fusarium rot among tested succulents.

Figure 4.
Symptoms induced by artificial inoculation of Neocosmospora falciformis on various succulent plants. (A) Crown rot on Ferocactus macrodiscus; (B) root and crown rot on Mammillaria bernalensis; (C) brown rot on Mammillaria prolifera; (D) root and crown rot on Mammillaria gracilis; (E) root and stem rot on Astrophytum asterias; (F) rotting, yellowing, and black spots on Mammillaria spinosissima; (G) crown rot on Opuntia ficus-indica; (H) chlorosis on Ferocactus macrodiscus; (I) chlorosis on Ferocactus glaucescens; (J) black spots on Echinocactus grusonii; (K) necrosis and black spots on the crown of Mammillaria bernalensis; and (L) root and crown rot on Aeonium arboreum.

Figure 5.
Symptoms induced by artificial inoculation of Fusarium oxysporum f. sp. opuntiarum on different succulent plants. (A–C) necrosis and yellowing on Echinocactus grusonii, Mammillaria spinosissima, and Opuntia fragilis, respectively; (D) discoloration and rotting on Hamatocactus setispinus (syn. Thelocactus setispinus); (E) root and crown rot with yellowing on Ferocactus emoryi; (F) rot and death of Echinocactus grusonii; (G) yellowing, discoloration, and crown rot on Stenocactus multicostatus; (H) root and crown rot as well as leaf dessication on Braunsia apiculata; (I) crown rot and yellowing on Mammillaria jaliscana; (J) root and crown rot on Mammillaria bernalensis; (K) root and crown rot on Sedum reflexum “Angelina”; (L) root and crown rot, yellowing, and necrotic area on Mammillaria gracilis; (M) yellowing and chlorosis on Astrophytum myriostigma; (N) root rot on Echinocactus grusonii; (O) crown rot, yellowing, and chlorosis on Mammillaria matudae; (P) dark-brown spots and soft rot on Carnegiea polylopha (syn. Neobuxbamia polylopha); (Q) soft rot on Astrophytum asterias; (R) black spots and stripes on Carnegiea polylopha; (S) root and crown rot on Aeonium arboreum; (T) black spots on crown and stem of Echinocactus grusonii; (U) root and crown rot, yellowing, and chlorosis on Astrophytum myriostigma; (V) chlorosis on Ferocactus macrodiscus; (W) root rot and drying on Sempervivum tectorum; and (X) root and crown rot as well as yellowing on Ferocactus emoryi.

Figure 6.
Symptoms induced by artificial inoculation of Fusarium proliferatum on different succulent plants. (A) rotting, yellowing, and girdling of the basal stem in Mammillaria prolifera; (B) root and crown rot on Mammillaria gracilis; (C) plant decline and death on Mammillaria pottsii; (D) crown rot and yellowing on Cephalocereus euphorbioides; (E) black spots on crown and stem of Echinocactus grusonii; (F) crown rot and yellowing on Astrophytum myriostigma; (G) crown rot and yellowing on Mammillaria gracilis; (H) basal sunken lesion and root rot in Hamatocactus setispinus (syn. Thelocactus setispinus); (I) plant decline from the top of the stem on Cereus jamacaru; (J) crown rot and yellowing on Echinocactus grusonii; (K)crown rot and yellowing on Mammillaria jaliscana; and (L) chlorosis and soft brown spots on Astrophytum myriostigma.
4. Discussion
Three species, namely F. oxysporum f. sp. opuntiarum, F. proliferatum, and N. falciformis, were found to be responsible for symptoms of dry and soft rot on succulent plants sampled during the survey of greenhouses in Shiraz County aimed at characterizing the diversity of fusarioid species associated with this disease. All three fungal species showed a wide range of natural hosts and an even broader spectrum of potential hosts, as shown by the results of artificial inoculations. The most common and polyphagous species was F. oxysporum f. sp. opuntiarum, a well-known pathogen of Cactaceae with a worldwide distribution, previously reported also in Iran but on a narrower range of host plants [17,27,49]. This f.sp. has been also reported as a pathogen of Euphorbia mammillaris var. variegata, a succulent plant of the family Euphorbiaceae [11]. Results of the present study further broaden the range of potential host plants of F. oxysporum f. sp. opuntiarum, extending it to members of the family Crassulaceae and Aizoaceae. Moreover, two other ff. spp. of F. oxysporum, f. sp. crassulae, and f. sp. echeveriae, both with a more restricted host range than F. oxysporum f. sp. opuntiarum, were reported as pathogens of Crassulaceae species [19,20]. This provides further evidence that the definition of f. sp. opuntiarum as well as of other F. oxysporum ff. spp. with a broad host range, based originally on host specificity and host range, is questionable and of limited diagnostic value if it is not supported by molecular and phylogenetic criteria [11,17,50,51,52]. The definition of ff. spp. of F. oxysporum in particular has become more challenging after the demonstration that some of them are polyphyletic [52,53,54,55].
Fusarium proliferatum, a polyphagous species whose host range spans from plants to animals [56,57], was already known as a pathogen of Cactaceae, having been reported as causal agent of stem rot and soft rot of Hylocereus polyrhizus (Weber) Britton and Rose and Echinopsis chamaecereus H. Friedrich and Glaetzie, respectively [18,58]. In this study, F. proliferatum was recovered from symptomatic plants of A. myriostigma, E. grusonii, F. gatesii, M. prolifera, M. vetula, and N. rutilans. Moreover, including plants that were susceptible to artificial infections, the host range of this Fusarium species also comprised C. euphorbioides, C. jumacaru, H. setispinus, M. gracilis, M. jaliscana, and M. potsii, all belonging to the family Cactaceae. None of these plants was previously reported as a host of F. proliferatum.
In the phylogenetic tree based on tef1 sequences, N. falciformis isolates recovered from succulent plants in Shiraz County clustered with diverse N. falciformis isolates from other studies [13,14,16,59]. According with the classification of the 80 species of the FSSC proposed by Geiser et al. [60], F. falciforme, the former name of N. falciformis, is a member of Clade 3, the largest clade of this species complex. Neocosmospora falciformis, besides being a plant pathogen, is a clinically relevant fungus capable of inducing disease on humans and animals generally as an opportunistic pathogen [13]. However, it includes also aggressive plant pathogens, such as the former F. paranaense, a species responsible for root rot of Glycine max in Brazil, which has been reduced in synonymy with N. falciformis after the phylogenetic revision of the genus Fusarium [13,61]. Moreover, under the name of F. falciforme, N. falciformis was reported as a pathogen of Phaseolus lunatus and was identified as one of the species associated with Fusarium wilt of Cannabis sativa and wilt and bud rot of A. tequilana [57,62,63]. The host range of N. falciformis isolates recovered in this study from naturally infected plants encompassed plant species of both Cactaceae and Crassulaceae families, including Ae. gomerense, C. euphorbioides, E. gibbiflora, E. minima, E. grusonii, E. pentacanthus, Gy. anisitsii, G. dansii, G. hostii, M. berlanensis, and N. leninghausii. In addition, the three tested isolates were pathogenic on artificially inoculated plants of As. asterias, Fe. glaucescens, Fe. macrodiscus, M. gracilis, M. spinosissima, and O. ficus-indica. To the best of our knowledge, this is the first time that N. falciformis is reported as a pathogen of Cactaceae and Crassulaceae species worldwide.
The three fusarioid species recovered from Cactaceae and other succulents in Shiraz County induced diverse types of symptoms. It can be speculated that some of these symptoms, such as wilt, yellowing, and necrotic spots on the stem, might have been induced by diffusible secondary toxic metabolites of these pathogens. Fusarium and Fusarium-like species are known to produce an array of toxins, including food contaminants, usually referred to as mycotoxins, and phytotoxins, i.e., toxins that can act as pathogenicity or virulence factors in plant diseases [64,65,66,67,68]. The ability to produce toxins was also used as an accessory taxonomic criterion to separate different genotypes within Fusarium species complexes [69,70,71]. Moreover, toxins were demonstrated to be responsible for host-specificity of diverse ff. spp. and races of Fusarium [72]. The production of host-specific phytotoxins is also a distinctive trait of ff. spp. and pathotypes of other toxin-producing fungi, such as Alternaria alternata [73]. Interestingly, F. proliferatum, one of the three fusarioid species recovered from succulents in Shiraz County, was shown to produce fusaproliferin, whose deacetylated derivative, named terpestatin or siccanol, was able to induce necrosis when injected on the stem of Opuntia ficus-indica [74,75]. Most probably, the characterization of phytotoxins produced by F. oxysporum f. sp. opuntiarum, F. proliferatum, and N. falciformis and the study of their role in the plant-pathogen interaction might provide new insights into the pathogenesis mechanisms of Fusarium rot of Cactaceae and other succulent plants.
Several factors favor the spread of Fusarium rot and make the management of this disease problematic in commercial greenhouses, including the involvement of multiple Fusarium and Fusarium-like species in the disease etiology, the ability of these fungi to switch to a saprophytic lifestyle and survive in soil on plant debris, their polyphagy facilitating cross-infections and, last but not least, vegetative propagation, which is the most commonly used method to propagate succulents in commercial nurseries.
5. Conclusions
Overall, results of this study confirm Fusarium and Fusarium-like species are a serious constraint for the commercial production of ornamental succulents under greenhouse conditions. Although F. oxysporum f. sp. opuntiarum was the prevalent species associated with Fusarim rot of succulents in surveyed commercial greenhouses of Shiraz County, the other two fungal species also recovered from infected plants, F. proliferatum and N. falciformis, were shown to be very aggressive on a wide range of succulents. Consistently with previous studies [11], results of pathogenicity tests indicate there are differences in susceptibility to Fusarium rot among species of succulents even within the same genus, as in the case of Mammillaria. Consequently, it can be assumed that planting species less susceptible to Fusarium rot may be a way to prevent and reduce the damage caused by this disease in commercial cultivations. Moreover, a better insight into the ecology and epidemiology of diverse fusarioid species associated with Fusarium rot of succulents as well as the characterization of putative pathogenicity-related genes of these fungi [76,77] may be useful to implement effective disease management strategies, such as the application of safe and effective natural antifungal preparation to control the disease [78].
Author Contributions
Conceptualization, S.K.-S., R.M.-G., F.S. and S.O.C.; methodology, S.K.-S., R.M.-G., F.S. and S.O.C.; software, F.S.; formal analysis, S.K.-S. and F.S.; investigation, S.K.-S. and F.S.; resources, R.M.-G. and S.O.C.; data curation, S.K.-S.; writing—original draft preparation, S.K.-S., R.M.-G. and F.S.; writing—review and editing, R.M.-G. and S.O.C.; supervision, R.M.-G. and S.O.C.; project administration, R.M.-G.; funding acquisition, R.M.-G. All authors have read and agreed to the published version of the manuscript.
Funding
This research was funded by the Centre for International Scientific Studies & Collaboration (CISSC), Ministry of Science, Research & Technology, Iran. This study was also funded by the University of Catania, Italy “Investigation of phytopathological problems of the main Sicilian productive contexts and eco-sustainable defense strategies (MED-IT-ECO)” PiaCeRi-PIAno di inCEntivi per la Ricerca di Ateneo 2020–2022 linea 2 (5A722192155) and by “Programma di cooperazione Italia Tunisia 2014–2020” project “PROMETEO «Un village transfrontalier: pour protéger les cultures arboricoles méditerranéennes en partageant les connaissances»; cod. C-5-2.1-36 CUP E25F21001180006”.
Institutional Review Board Statement
Not applicable.
Informed Consent Statement
Not applicable.
Data Availability Statement
Not applicable.
Acknowledgments
The authors thank the Italy-Iran (2018–2019) mobility Program “PIETRO DELLA VALLE” “Pomegranate and pistachio diseases and selection of ecotypes resistant to fungal diseases in Iran” for providing the funds for the collaboration. The authors are grateful to A. Davis for the English revision of the text.
Conflicts of Interest
The authors declare no conflict of interest. The funders had no role in the design of the study; in the collection, analyses, or interpretation of data; in the writing of the manuscript, or in the decision to publish the results.
References
- Eggli, U. Illustrated Handbook of Succulent Plants: Dicotyledons; Springer: Berlin/Heidelberg, Germany, 2004; pp. 1–3. [Google Scholar]
- Albers, F.; Meve, U. Asclepiadaceae. In Illustrated Handbook of Succulent Plants: Aizoaceae A–E.; Albers, F., Meve, U., Eds.; Springer: Berlin/Heidelberg, Germany, 2002; pp. 5–8. [Google Scholar]
- Hartmann, K.E.K. Aizoaceae. In Illustrated Handbook of Succulent Plants: Aizoaceae A–E.; Hartmann, K.E.K., Ed.; Springer: Berlin/Heidelberg, Germany, 2002; pp. 9–268. [Google Scholar]
- Eggli, U. Crassulaceae. In Illustrated Handbook of Succulent Plants: Crassulaceae; Eggli, U., Ed.; Springer: Berlin/Heidelberg, Germany, 2003; pp. 5–8. [Google Scholar]
- Charles, G. Cacti and Succulents: An Illustrated Guide to the Plants and Their Cultivation; Crowood Press: Ramsbury, UK, 2014; 192p. [Google Scholar]
- Christenhusz, M.J.; Byng, J.W. The number of known plant species in the world and its annual increase. Phytotaxa 2016, 261, 201–217. [Google Scholar] [CrossRef] [Green Version]
- Kaplan, H.; Wilson, J.R.U.; Klein, H.; Henderson, L.; Zimmermann, H.G.; Manyama, P.; Ivey, P.; Richardson, D.M.; Novoa, A. A proposed national strategic framework for the management of Cactaceae in South Africa. Bothalia 2017, 47, 1–12. [Google Scholar] [CrossRef]
- Ochoa, M.J.; Barbera, G. History and Economic and Agro-Ecological Importance. In Crop Ecology, Cultivation and Uses of Cactus Pear; Inglese, P., Mondragon, C., Nefzaoui, A., Saenz, C., Eds.; FAO: Rome, Italy; ICARDA: Beirut, Lebanon, 2017; pp. 1–12. [Google Scholar]
- Wick, R.L. Diseases of Holiday Cacti: Schlumbergera and Hatiora. In Handbook of Florists’ Crops Diseases, Handbook of Plant Disease Management Series; McGovern, R., Elmer, W., Eds.; Springer: New York, NY, USA, 2017; pp. 976–986. [Google Scholar]
- Aloi, F.; Giambra, S.; Schena, L.; Surico, G.; Pane, A.; Gusella, G.; Stracquadanio, C.; Burruano, S.; Cacciola, S.O. New insights into scabby canker of Opuntia ficus-indica, caused by Neofusicoccum batangarum. Phytopathol. Mediterr. 2020, 59, 269–284. [Google Scholar]
- Bertetti, D.; Ortu, G.; Gullino, M.L.; Garibaldi, A. Identification of Fusarium oxysporum f. sp. opuntiarum on new hosts of the Cactaceae and Euphorbiaceae families. J. Plant Pathol. 2017, 99, 347–354. [Google Scholar]
- Lombard, L.; van der Merwe, N.A.; Groenewald, J.Z.; Crous, P. Generic concepts in Nectriaceae. Stud. Mycol. 2015, 80, 189–245. [Google Scholar] [CrossRef] [Green Version]
- Sandoval-Denis, M.; Lombard, L.; Crous, P. Back to the roots: A reappraisal of Neocosmospora. Persoonia 2019, 43, 90–185. [Google Scholar] [CrossRef]
- O’Donnell, K. Molecular phylogeny of the Nectria haematococca–Fusarium solani species complex. Mycologia 2000, 92, 919–938. [Google Scholar] [CrossRef]
- Geiser, D.M.; Aoki, T.; Bacon, C.W.; Baker, S.E.; Bhattacharyya, M.K.; Brandt, M.E.; Brown, D.W.; Burgess, L.W.; Chulze, S.; Coleman, J.J.; et al. One fungus, one name: Defining the genus Fusarium in a scientifically robust way that preserves longstanding use. Phytopathology 2013, 103, 400–408. [Google Scholar] [CrossRef] [Green Version]
- O’Donnell, K.; Al-Hatmi, A.M.S.; Aoki, T.; Brankovics, B.; Cano-Lira, J.F.; Coleman, J.J.; de Hoog, G.S.; Di Pietro, A.; Frandsen, R.J.N.; Geiser, D.M.; et al. No to Neocosmospora: Phylogenomic and practical reasons for continued inclusion of the Fusarium solani species complex in the genus Fusarium. Mycosphere 2020, 5, e00810-20. [Google Scholar] [CrossRef]
- Edel-Hermann, V.; Lecomte, C. Current Status of Fusarium oxysporum Formae Speciales and Races. Phytopathology 2019, 109, 512–530. [Google Scholar] [CrossRef] [Green Version]
- Hawa, M.; Salleh, B.; Latiffah, Z. Characterization and pathogenicity of Fusarium proliferatum causing stem rot of Hylocereus polyrhizus in Malaysia. Ann. Appl. Biol. 2013, 163, 269–280. [Google Scholar] [CrossRef]
- Ortu, G.; Bertetti, D.; Gullino, M.L.; Garibaldi, A. A new forma specialis of Fusarium oxysporum on Crassula ovata. J. Plant Pathol. 2013, 95, 33–39. [Google Scholar]
- Ortu, G.; Bertetti, D.; Gullino, M.L.; Garibaldi, A. Fusarium oxysporum f. sp. echeveriae, a novel forma specialis causing crown and stem rot of Echeveria agavoides. Phytopathol. Mediterr. 2015, 54, 64–75. [Google Scholar]
- Masratul Hawa, M.; Nurul Faziha, I.; Nik Mohamad Izham, M.N.; Latiffah, Z. Fusarium fujikuroi associated with stem rot of red-fleshed dragon fruit (Hylocereus polyrhizus) in Malaysia Ann. Appl. Biol. 2017, 170, 434–446. [Google Scholar] [CrossRef]
- Wright, E.R.; Rivera, M.C.; Ghirlanda, A.; Lori, G.A. Basal rot of Hylocereus undatus caused by Fusarium oxysporum in Buenos Aires, Argentina. Plant Dis. 2007, 91, 323. [Google Scholar] [CrossRef]
- Vakalounakis, D.J.; Kavroulakis, N.; Lamprou, K. First report of Fusarium oxysporum causing root and crown rot on barbados aloe in Greece. Plant Dis. 2015, 99, 1649. [Google Scholar] [CrossRef]
- Ramírez-Ramírez, M.; Mancilla-Margalli, N.A.; Meza-Álvarez, L.; Turincio-Tadeo, R.; Guzmán-de Pena, D.; Avila-Miranda, M.E. Epidemiology of Fusarium agave wilt in Agave tequilana Weber var. azul. Plant Protect. Sci. 2017, 53, 144–152. [Google Scholar]
- Ogórek, R.; Piecuch, A.; Kędzior, M. Fusarium oxysporum as a pathogen of pot plants: A case study of the easter lily cactus (Echinopsis oxygona) in Poland. Pol. J. Environ. Stud. 2021, 30, 2701–2708. [Google Scholar] [CrossRef]
- Bertetti, D.; Pensa, P.; Matic, S.; Gullino, M.L.; Garibaldi, A. Stem rot caused by Fusarium oxysporum f. sp. opuntiarum on Mammillaria painteri in Italy. Phytopathol. Mediter. 2020, 59, 365–369. [Google Scholar]
- Safaiefarahani, B.; Mostowfizadeh-Ghalamfarsa, R. Identification and morphological characterization of Fusarium oxysporum f. sp. opuntiarum, the causal agent of basal stem rot of cactus in Fars province. Iran J. Plant Pathol. 2014, 50, 409–410. [Google Scholar]
- Jeffers, S.N.; Martin, S.B. Comparision of two media selective for Phytophthora and Pythium species. Plant Dis. 1986, 70, 1035–1043. [Google Scholar] [CrossRef]
- Choi, Y.W.; Hyde, K.D.; Ho, W.H. Single spore isolation of fungi. Fungal Divers. 1999, 3, 29–38. [Google Scholar]
- Aoki, T.; O’Donnell, K.; Homma, Y.; Lattanzi, A.R. Sudden-death syndrome of soybean is caused by two morphologically and phylogenetically distinct species within the Fusarium solani species complex—F. virguliforme in North America and F. tucumaniae in South America. Mycologia 2003, 95, 660–684. [Google Scholar] [CrossRef] [Green Version]
- Aoki, T.; O’Donnell, K.; Scandiani, M.M. Sudden death syndrome of soybean in South America is caused by four species of Fusarium: Fusarium brasiliense sp. nov., F. cuneirostrum sp. nov., F. tucumaniae and F. virguliforme. Mycologia 2005, 46, 162–183. [Google Scholar] [CrossRef]
- Leslie, J.F.; Summerell, B.A. The Fusarium Laboratory Manual; Blackwell: Ames, IA, USA, 2006; 388p. [Google Scholar]
- Thompson, R.S.; Aveling, T.A.S.; Blanco Prieto, R. A new semi-selective medium for Fusarium graminearum, F. proliferatum, F. subglutinans and F. verticillioides in maize seed. S. Afr. J. Bot. 2013, 84, 94–101. [Google Scholar] [CrossRef]
- Fisher, N.L.; Burgess, L.W.; Toussoun, T.A.; Nelson, P.E. Carnation leaves as a substrate and for preserving cultures of Fusarium species. Phytopathology 1982, 72, 151–153. [Google Scholar] [CrossRef]
- Yilmaz, N.; Sandoval-Denis, M.; Lombard, L.; Visagie, C.M.; Wingfield, B.D.; Crous, P.W. Redefining species limits in the Fusarium fujikuroi species complex. Persoonia 2021, 46, 129–162. [Google Scholar] [CrossRef]
- Nelson, P.E.; Toussoun, T.A.; Cook, R.J. Fusarium: Diseases, Biology and Taxonomy; The Pennsylvania State University Press: University Park, PA, USA, 1982; 474p. [Google Scholar]
- Schena, L.; Abdelfattah, A.; Mosca, S.; Li Destri, G.; Agosteo, G.E.; Cacciola, S.O. Quantitative detection of Colletotrichum godetiae and C. acutatum sensu stricto in the phyllosphere and carposphere of olive during four phenological phases. Eur. J. Plant Pathol. 2017, 149, 337–347. [Google Scholar] [CrossRef]
- O’Donnell, K.; Sutton, D.A.; Rinaldi, M.G.; Sarver, B.A.; Balajee, S.A.; Schroers, H.J.; Summerbel, R.C.; Varg, R.; Crous, P.W.; Zhang, N.; et al. Internet-accessible DNA sequence database for identifying Fusaria from human and animal infections. J. Clin. Microbiol. 2010, 48, 3708–3718. [Google Scholar] [CrossRef] [Green Version]
- Hall, T.A. BioEdit: A user-friendly biological sequence alignment editor and analysis program for Windows 95/98/NT. In Nucleic Acids Symposium Series; Information Retrieval Ltd.: London, UK, 1999; pp. 95–98. [Google Scholar]
- Thompson, J.D.; Gibson, T.J.; Plewniak, F.; Jeanmougin, F.; Higgins, D.G. The ClustalX windows interface: Flexible strategies for multiple sequence alignment aided by quality analysis tools. Nucleic Acids Res. 1997, 25, 4876–4882. [Google Scholar] [CrossRef] [Green Version]
- Ronquist, F.; Huelsenbeck, J.P. MrBayes 3: Bayesian phylogenetic inference under mixed models. Bioinformatics 2003, 19, 1572–1574. [Google Scholar] [CrossRef] [PubMed] [Green Version]
- Salmaninezhad, F.; Mostowfizadeh-Ghalamfarsa, R. Three new Pythium species from rice paddy fields. Mycologia 2019, 111, 274–290. [Google Scholar] [CrossRef] [PubMed]
- Nylander, J.A.; Ronquist, F.; Huelsenbeck, J.P.; Nieves-Aldrey, J. Bayesian phylogenetic analysis of combined data. Systematic Biol. 2004, 53, 47–67. [Google Scholar] [CrossRef] [PubMed] [Green Version]
- Mishra, B.; Ploch, S.; Weiland, C.; Thines, M. TrEase—A Webserver to Infer Phylogenetic Trees with Ease. Available online: http://www.thines-lab.senckenberg.de/trease (accessed on 14 January 2022).
- Stöver, B.C.; Müller, K.F. TreeGraph 2: Combining and visualizing evidence from different phylogenetic analyses. BMC Bioinform. 2010, 11, 1–9. [Google Scholar] [CrossRef] [Green Version]
- TreeBASE. Available online: http://www.treebase.org (accessed on 14 January 2022).
- Sabahi, F. Invenstivigation of Fungal and Fungal-like Soil Borne Pathogens Causal Agents of Oranamentals Mortality in Shiraz. Master’s Thesis, Shiraz University, Shiraz, Iran, 2013. [Google Scholar]
- Westerlund, F.V.; Campbell, R.N.; Kimble, K.A. Fungal root rots and wilt of chickpea in California. Phytopathology 1974, 64, 432–436. [Google Scholar]
- Gerlach, W. Fusarium rot and other fungal diseases of horticulturally important cacti in Germany. Phytopathol. Z. 1972, 74, 197–217. [Google Scholar]
- Van Dam, P.; Fokkens, L.; Schmidt, S.M.; Linmans, J.H.; Kistler, H.C.; Ma, L.J.; Rep, M. Effector profiles distinguish formae speciales of Fusarium oxysporum. Environ. Microbiol. 2016, 18, 4087–4102. [Google Scholar] [CrossRef]
- Lievens, B.; Hanssen, I.M.; Rep, M. Recent developments in the detection and identification of formae speciales and races of Fusarium oxysporum: From pathogenicity testing to molecular diagnostics. In Fusarium Wiltings of Vegetable and Ornamental Crops; Gullino, M.L., Katan, J., Garibaldi, A., Eds.; APS Press: St. Paul, MN, USA, 2017; pp. 47–55. [Google Scholar]
- Duan, Y.; Qu, W.; Chang, S.; Li, C.; Xu, F.; Ju, M.; Zhao, R.; Wang, H.; Zhang, H.; Miao, H. Identification of pathogenicity groups and pathogenic molecular characterization of Fusarium oxysporum f. sp. Sesame in China. Phytopathology 2020, 110, 1093–1104. [Google Scholar] [CrossRef]
- O’Donnell, K.; Kistler, H.C.; Cigelnik, E.; Ploetz, R.C. Multiple evolutionary origin of the fungus causing panama disease of banana: Concordant evidence from nuclear and mitochondrial gene genealogies. Proc. Nat. Acad. Sci. USA 1998, 95, 2044–2049. [Google Scholar] [CrossRef] [Green Version]
- Baayen, R.P.; O’Donnell, K.; Bonants, P.J.M.; Cigelnik, E.; Kroon, L.P.N.M.; Roebroeck, E.J.A.; Waalwijk, C. Gene genealogies and AFLP analyses in the Fusarium oxysporum complex identify monophyletic and non-monophyletic formae speciales causing wilt and rot disease. Phytopathology 2000, 90, 891–900. [Google Scholar] [CrossRef] [Green Version]
- Skovgaard, K.; Nirenberg, H.I.; O’Donnell, K.; Rosendahl, S. Evolution of Fusarium oxysporum f. sp. vasinfectum races inferred from multigene genealogies. Phytopathology 2001, 91, 1231–1237. [Google Scholar]
- Chehri, K. Molecular identification of entomopathogenic Fusarium species associated with Tribolium species in stored grains. J. Invertebr. Pathol. 2017, 144, 1–6. [Google Scholar] [CrossRef]
- Gwinn, K.D.; Hansen, Z.; Kelly, H.; Ownley, B.H. Diseases of Cannabis sativa caused by diverse Fusarium species. Front. Agron. 2022, 3, 796062. [Google Scholar] [CrossRef]
- Narmani, A.; Arzanlou, M.; Babai Ahari, A.; Hatef, H.; Ghasemi, S. First report of fungal soft rot disease caused by Fusarium proliferatum on peanut cactus (Echinopsis chamaecereus) in the world. In Proceedings of the 22nd Iranian Plant Protection Congress, College of Agriculture and Natural Resources, Karaj, Iran, 27–30 August 2016; University of Tehran: Karaj, Iran, 2016; p. 202. [Google Scholar]
- O’Donnell, K.; Sutton, D.A.; Fothergill, A.; McCarthy, D.; Rinaldi, M.G.; Brandt, M.E.; Zhang, N.; Geiser, D.M. Molecular phylogenetic diversity, multilocus haplotype nomenclature, and in vitro antifungal resistance within the Fusarium solani species complex. J. Clin. Microbiol. 2008, 46, 2477–2490. [Google Scholar] [CrossRef] [Green Version]
- Geiser, D.M.; Al-Hatmi, A.M.S.; Aoki, T.; Arie, T.; Balmas, V.; Barnes, I.; Bergstrom, G.C.; Bhattacharyya, M.K.; Blomquist, C.L.; Bowden, R.L.; et al. Phylogenomic analysis of a 55.1 kb 19-gene dataset resolves a monophyletic Fusarium that includes the Fusarium solani species complex. Phytopathology 2021, 111, 1064–1079. [Google Scholar] [CrossRef]
- Costa, S.S.; Matos, K.S.; Tessmann, D.J.; Seixas, C.D.; Pfenning, L.H. Fusarium paranaense sp. nov., a member of the Fusarium solani species complex causes root rot on soybean in Brazil. Fungal Biol. 2016, 120, 51–60. [Google Scholar] [CrossRef]
- Sousa, E.S.; Melo, M.P.; Mota, J.M.; Sousa, E.M.J.; Beserra, J.E.A.; Matos, K.S. First report of Fusarium falciforme (FSSC 3 + 4) causing root rot in lima bean (Phaseolus lunatus L.) in Brazil. Plant Dis. 2017, 101, 1954. [Google Scholar] [CrossRef]
- López-Bautista, V.; Mora-Aguilera, G.; Gutiérrez-Espinosa, M.A.; Mendoza-Ramos, C.; Martínez-Bustamante, V.I.; Coria-Contreras, J.J.; Acevedo-Sánchez, G.; Santana-Peñaloza, B. Morphological and molecular characterization of Fusarium spp. associated to the regional occurrence of wilt and dry bud rot in Agave tequilana. Mex. J. Phytopathol. 2020, 38, 79–106. [Google Scholar] [CrossRef]
- Nesic, K.; Ivanovic, S.; Nesic, V. Fusarial toxins: Secondary metabolites of Fusarium fungi. Rev. Environ. Contam. Toxicol. 2014, 228, 101–120. [Google Scholar]
- Chang, H.-X.; Domier, L.L.; Radwan, O.; Yendrek, C.R.; Hudson, M.E.; Hartman, G.L. Identification of multiple phytotoxins produced by Fusarium virguliforme including a phytotoxic effector (FvNIS1) associated with sudden death syndrome foliar symptoms. MPMI 2016, 29, 96–108. [Google Scholar] [CrossRef] [Green Version]
- Perincherry, L.; Lalak-Kańczugowska, J.; Stępień, Ł. Fusarium-produced mycotoxins in plant-pathogen interactions. Toxins 2019, 11, 664. [Google Scholar] [CrossRef] [Green Version]
- Bentivenga, G.; Spina, A.; Ammar, K.; Allegra, M.; Cacciola, S.O. Screening of durum wheat (Triticum turgidum L. subsp. durum (Desf.) Husn.) Italian cultivars for susceptibility to fusarium head blight incited by Fusarium graminearum. Plants 2021, 10, 68. [Google Scholar]
- Stracquadanio, C.; Luz, C.; La Spada, F.; Meca, G.; Cacciola, S.O. Inhibition of mycotoxigenic fungi in different vegetable matrices by extracts of Trichoderma Species. J. Fungi 2021, 7, 445. [Google Scholar] [CrossRef]
- Somma, S.; Petruzzella, A.L.; Logrieco, A.F.; Meca, G.; Cacciola, S.O.; Moretti, A. Phylogenetic analyses of Fusarium graminearum strains from cereals in Italy, and characterisation of their molecular and chemical chemotypes. Crop Pasture Sci. 2014, 65, 52–60. [Google Scholar] [CrossRef]
- Nirmaladevi, D.; Venkataramana, M.; Srivastava, R.; Uppalapati, S.R.; Gupta, V.K.; Yli-Mattila, T.; Tsui, K.M.C.; Srinivas, C.; Niranjana, S.R.; Chandra, N.S. Molecular phylogeny, pathogenicity and toxigenicity of Fusarium oxysporum f. sp. lycopersici. Sci. Rep. 2016, 6, 21367. [Google Scholar] [CrossRef] [Green Version]
- Pasquali, M.; Beyer, M.; Logrieco, A.; Audenaert, K.; Balmas, V.; Basler, R.; Boutigny, A.-L.; Chrpová, J.; Czembor, E.; Gagkaeva, T.; et al. A European database of Fusarium graminearum and F. culmorum trichothecene genotypes. Front. Microbiol. 2016, 7, 406. [Google Scholar] [CrossRef] [Green Version]
- Sutherland, M.L.; Pegg, G.F. Purification of a toxin from Fusarium oxysporum f. sp. lycopersici race 1. Physiol. Mol. Plant Pathol. 1995, 46, 243–254. [Google Scholar] [CrossRef]
- Aloi, F.; Riolo, M.; Sanzani, S.M.; Mincuzzi, A.; Ippolito, A.; Siciliano, I.; Pane, A.; Gullino, M.L.; Cacciola, S.O. Characterization of Alternaria Species Associated with Heart Rot of Pomegranate Fruit. J. Fungi 2021, 7, 172. [Google Scholar] [CrossRef]
- Masi, M.; Aloi, F.; Nocera, P.; Cacciola, S.O.; Surico, G.; Evidente, A. Phytotoxic metabolites isolated from Neofusicoccum batangarum, the causal agent of the scabby canker of cactus pear (Opuntia ficus-indica L.). Toxins 2020, 12, 126. [Google Scholar] [CrossRef] [PubMed] [Green Version]
- Ćeranić, A.; Svoboda, T.; Berthiller, F.; Sulyok, M.; Samson, J.M.; Güldener, U.; Schuhmacher, R.; Adam, G. Identification and functional characterization of the gene cluster responsible for fusaproliferin biosynthesis in Fusarium proliferatum. Toxins 2021, 13, 468. [Google Scholar] [CrossRef]
- Lievens, B.; Houterman, P.M.; Rep, M. Effector gene screening allows unambiguous identification of Fusarium oxysporum f. sp. lycopersici races and discrimination from other formae speciales. FEMS Microbiol. Lett. 2009, 300, 201–215. [Google Scholar] [PubMed] [Green Version]
- Taylor, A.; Vágány, V.; Jackson, A.C.; Harrison, R.J.; Rainoni, A.; Clarkson, J.P. Identification of pathogenicity-related genes in Fusarium oxysporum f. sp. cepae. Mol. Plant Pathol. 2015, 17, 1032–1047. [Google Scholar] [CrossRef] [PubMed] [Green Version]
- Pangallo, S.; Li Destri Nicosia, M.G.; Agosteo, G.E.; Abdelfattah, A.; Romeo, F.V.; Cacciola, S.O.; Rapisarda, P.; Schena, L. Evaluation of a pomegranate peel extract (PGE) as alternative mean to control olive anthracnose. Phytopathology 2017, 107, 1462–1467. [Google Scholar] [CrossRef] [PubMed] [Green Version]
Publisher’s Note: MDPI stays neutral with regard to jurisdictional claims in published maps and institutional affiliations. |
© 2022 by the authors. Licensee MDPI, Basel, Switzerland. This article is an open access article distributed under the terms and conditions of the Creative Commons Attribution (CC BY) license (https://creativecommons.org/licenses/by/4.0/).